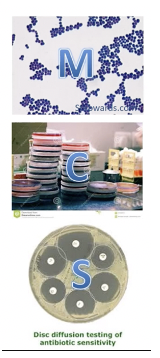

If a disease is rare, more likely a false positive or negative?
The risk of false negative and false positive changes with how frequently a disease is seen in the community (and with the quality of a test). In simple terms, if a disease is very rare, a false positive is more likely and should be corroborated with other information

What is sensitivity?
The proportion of people with the disease who have a positive test
A/(A + B)

What is specificity?
The proportion of people without the disease who have a negative test
D/(C + D)

What are M, C and S?
Microscopy culture and sensitivity
What is microscopy?
What is culture?
What is sensitivity in terms of M, C and S?
Many samples – pus, blood, sputum, urine – are sent for MCS, but what does that mean?
What are blood tests for detection for immunity?
What are blood tests for detection of a pathogen?
What are the generic tests?
What are speficifc tests for infections?
What are CNS infections?
What is meningitis/ encephalitis?
Inflammation of the meninges/brain parenchyma
How do we test for meningitis/ encephelitis?
Treatment for meningitis/ encephalitis?
GIVE BROAD SPECTURM ANTIBIOTICS STRAIGHT AWAY DUE TO THE HIGH MORTALITY. THEN RESULTS OF CSF THEN THEN DECIDE WHAT TO GIVE
What do CSF tests test for in meningitis/ encephalitis?
What are other tests other for CSF if CSF suggests meningitis/ encephalitis?
What are non-CSF tests to test for meningitis/ encephalitis?
What bacteria if adult has meningitis?
Adults if have meningitis- would have S. pneumoniae or N. meningitidis
Elderly and neonates what bacteria if have meningits/ encephalitis?
Adults if have meningitis- would have S. pneumoniae or N. meningitidis, elderly have listeria, neonates would have Group B strep Agalactiae, E. coli and listeria.
How do you test for meningitis and encephalitis?
n brain abscesses, there are a number of mechanisms of infection what are they?
What are symptoms of upper RTIs?
Upper is common cold, sore throats, ear infections